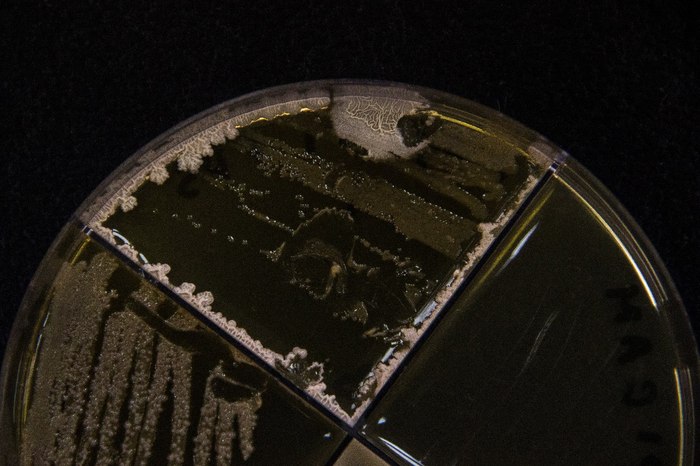

Мурманск
Удалось побывать в очень интересном городе. И знаете, никогда бы не подумала, что Мурманск может вот так влюбить в себя.
Вообще каждый город в России может зацепить вас чем-то. И пусть это будет какая-то глушь, или шумный мегаполис, есть своя изюминка у всех. Но сейчас не об этом. Сам город построен на сопках, что и добавляет ему своего обаяния.
Отчётливо помню запах железной дороги, соли и... рыбы. И нет, это я не отношу к отрицательному качеству.
Там есть замечательная смотровая площадка, на которой установлен этот маяк. Он в рабочем состояние, но его не используют из-за его расположения. Читала, что это символ спокойной жизни на берегу и дань памяти тем, кто не вернулся из морей.
А ещё архитектура! Как-будто попадаешь в советское время. И это тебя пленит. Простой, просторный город, в котором ты действительно чувствуешь себя свободным. Пусть это и самый крупный северный город за полярным кругом, но знаете, есть та атмосфера, которая греет душу.
И не стоит забывать, что это город-порт.
Возможно всё это как-то сумбурно, но! столько времени прошло с моей поездки, а впечатлений море. И хочется погостить там снова.
А вот это бонусом, по пути обратно:
Фотографии мои, текст мой. Это личное мнение туриста, которому посчастливилось там побывать три дня.
Не судите строго, я очень старалась для вас!